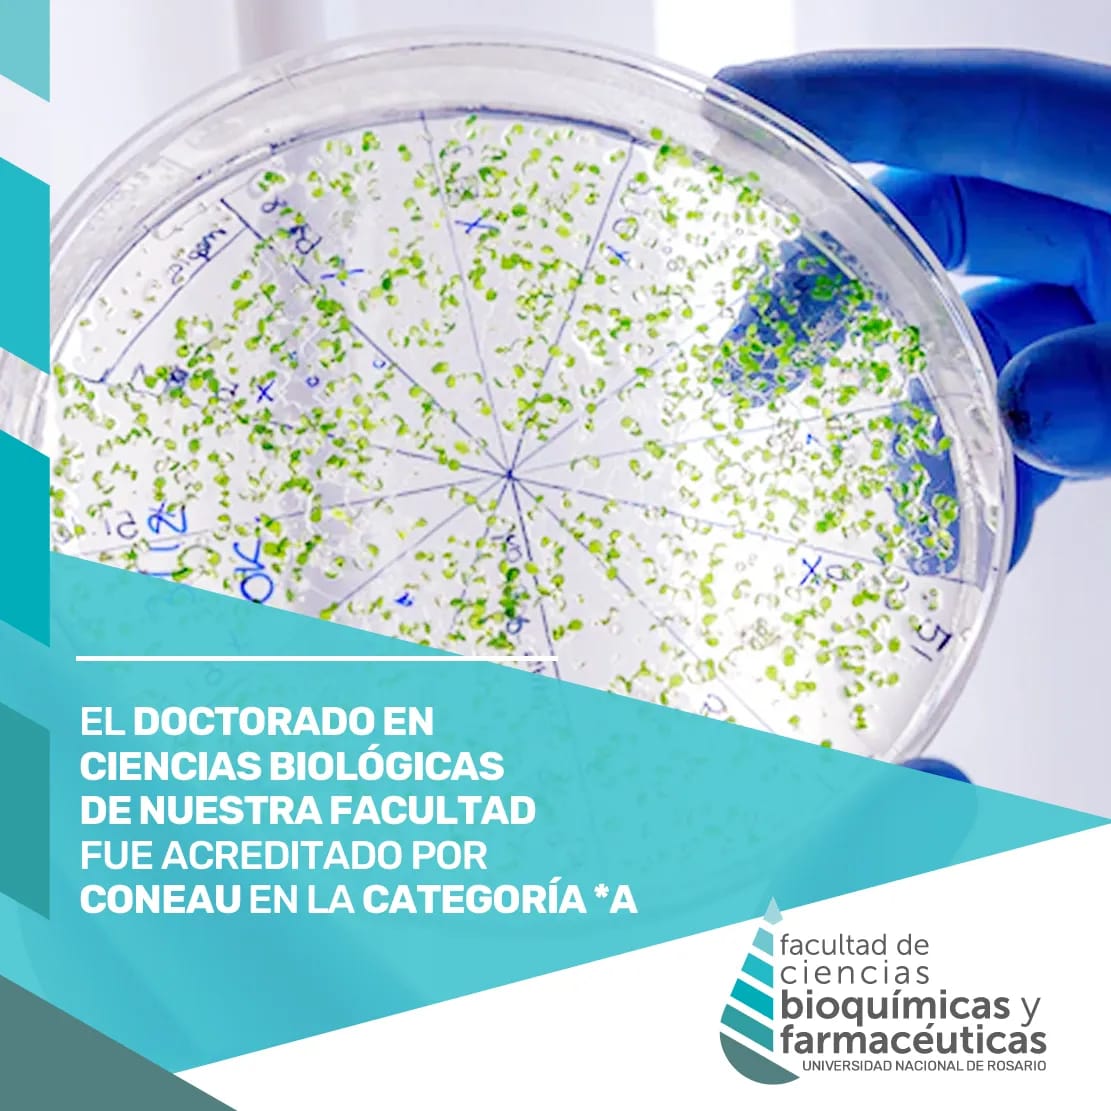
FBIOyF UNR Facultad Cs Bioquímicas y Farmacéuticas tweet media

Valeria Campos Bermudez
166 posts

Valeria Campos Bermudez
@VCB_arg
Biotecnologa, docente, madre,







Desde Academia Joven de Argentina manifestamos nuestra preocupación ante el discurso brindado por el vocero presidencial, Manuel Adorni @madorni, que tuvo por finalidad cuestionar la pertinencia del apoyo brindado a la comunidad científica local por parte de 68 Premios Nobel.


👉68 prestigiosos científicos y científicas ganadores del @NobelPrize firmaron una carta en apoyo al sistema científico argentino y contra el feroz ajuste al que lo está sometiendo el gobierno nacional. nexciencia.exactas.uba.ar/carta-68-premi…







Join us in congratulating the 65 fellows newly elected to the American Academy of Microbiology! Fellows are elected annually through a selective, peer-review process based on their scientific achievements and original contributions. asm.social/12B

Be Part of our Team and play with our brand new @LICOR_ENV #licor6800 @CEFOBI_CONICET to unveil why are "plants" are "climate-resilient"! 🍃☄️⛈️🌩️☔️❄️💥 @CCfusari @NicoEBlanco #photosynthesis @agenciaidiar